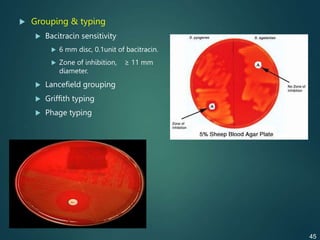
 Grouping & typing
 Bacitracin sensitivity
 6 mm disc, 0.1unit of bacitracin.
 Zone of inhibition, ≥ 11 mm
diameter.
 Lancefield grouping
 Griffith typing
 Phage typing
45
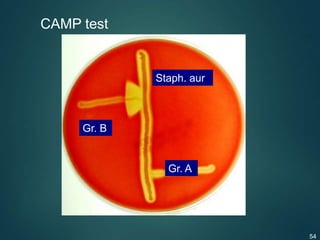
CAMP test
Staph. aur
Gr. B
Gr. A
54

The document provides a comprehensive overview of pharyngitis, particularly focusing on its etiological agents such as Streptococcus pyogenes and other bacterial causes. It discusses the viral and bacterial origins of the disease, their classification, cultural characteristics, pathogenicity, virulence factors, epidemiology, and associated diseases including both suppurative and nonsuppurative effects. Additionally, it covers laboratory diagnosis, treatment options, and preventive measures for rheumatic fever and other complications.